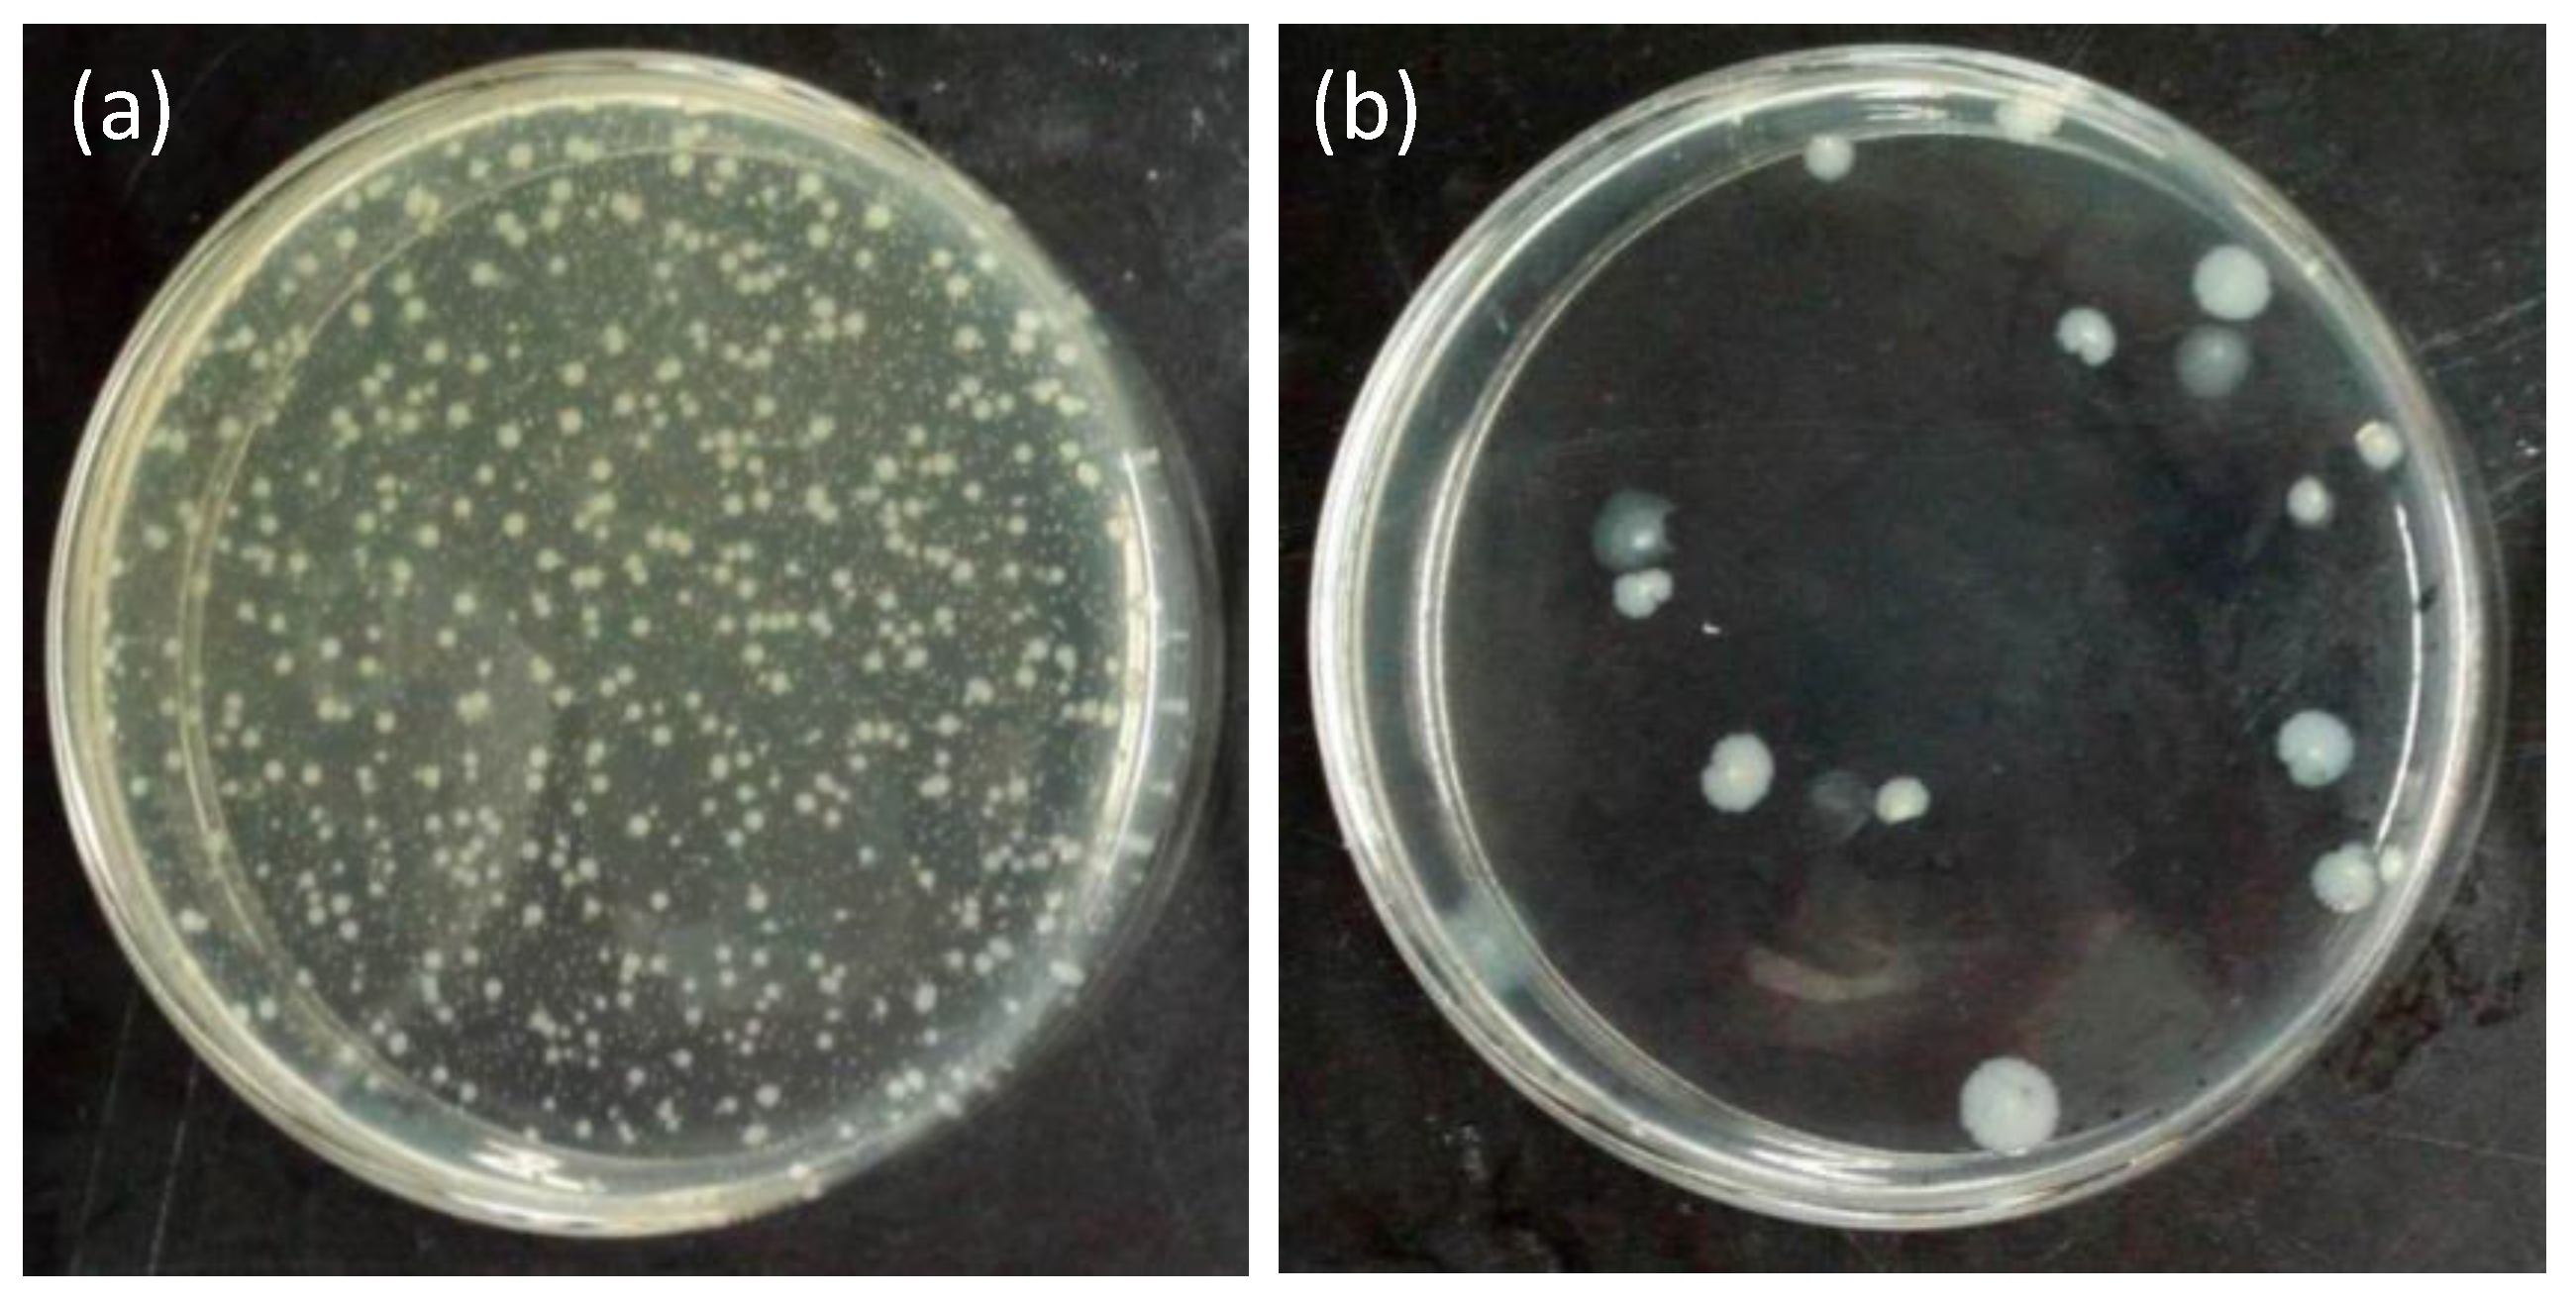
Materials 11 01929 g010

Functionalization of Silk with In-Situ Synthesized Platinum Nanoparticles
Abstract
:1. Introduction
2. Materials and Methods
2.1. Materials
2.2. In-Situ Synthesis of PtNPs on Silk Fabrics
2.3. Characterization Instrument
2.4. Color Fastness to Washing and Rubbing
2.5. Catalytic Activity
2.6. Antibacterial Test Against Gram-Negative Bacteria
3. Results and Discussion
3.1. Preparation and Characterization of the Silk Fabrics with PtNPs
3.2. Influence of pH Value and Temperature
3.3. Assessment of Color Fastness
3.4. Investigation of Catalytic Activity
3.5. Antibacterial Properties
4. Conclusions
Author Contributions
Funding
Conflicts of Interest
References
- Fakoori, E.; Karami, H. Preparation and characterization of ZnO-PP nanocomposite fibers and non-woven fabrics. Text. Res. J. 2018, 109, 1152–1158. [Google Scholar] [CrossRef]
- Abidi, N.; Cabrales, L.; Hequet, E. Functionalization of a cotton fabric surface with titania nanosols: Applications for self-cleaning and uv-protection properties. ACS Appl. Mater. Interfaces 2009, 1, 2141–2146. [Google Scholar] [CrossRef] [PubMed]
- Becheri, A.; Durr, M.; Lo Nostro, P.; Baglioni, P. Synthesis and characterization of zinc oxide nanoparticles: Application to textiles as uv-absorbers. J. Nanopart. Res. 2008, 10, 679–689. [Google Scholar] [CrossRef]
- Tang, B.; Yao, Y.; Chen, W.; Chen, X.; Zou, F.; Wang, X. Kinetics of dyeing natural protein fibers with silver nanoparticles. Dyes Pigments 2017, 148, 224–235. [Google Scholar] [CrossRef]
- Tang, B.; Sun, L.; Kaur, J.; Yu, Y.; Wang, X. In-situ synthesis of gold nanoparticles for multifunctionalization of silk fabrics. Dyes Pigments 2014, 103, 183–190. [Google Scholar]
- Kebede, M.A.; Imae, T.; Sabrina; Wu, C.-M.; Cheng, K.-B. Cellulose fibers functionalized by metal nanoparticles stabilized in dendrimer for formaldehyde decomposition and antimicrobial activity. Chem. Eng. J. 2017, 311, 340–347. [Google Scholar] [CrossRef]
- Tang, B.; Yao, Y.; Li, J.; Qin, S.; Zhu, H.; Kaur, J.; Chen, W.; Sun, L.; Wang, X. Functional application of noble metal nanoparticles in situ synthesized on ramie fibers. Nanoscale Res. Lett. 2015, 10, 366. [Google Scholar] [CrossRef] [PubMed]
- Wu, X.Y.; Shi, Z.Q.; Fu, S.D.; Chen, J.L.; Berry, R.M.; Tam, K.C. Strategy for synthesizing porous cellulose nanocrystal supported metal nanocatalysts. ACS Sustain. Chem. Eng. 2016, 4, 5929–5935. [Google Scholar]
- Yun, G.; Pan, S.; Wang, T.Y.; Guo, J.; Richardson, J.J.; Caruso, F. Synthesis of metal nanoparticles in metal-phenolic networks: Catalytic and antimicrobial applications of coated textiles. Adv. Healthc. Mater. 2017, 7, 1700934. [Google Scholar] [CrossRef] [PubMed]
- Laiho, T.; Leiro, J.A.; Lukkari, J. XPS study of irradiation damage and different metal–sulfur bonds in dodecanethiol monolayers on gold and platinum surfaces. Appl. Surf. Sci. 2003, 212–213, 525–529. [Google Scholar]
- Dablemont, C.; Lang, P.; Mangeney, C.; Piquemal, J.-Y.; Petkov, V.; Herbst, F.; Viau, G. FTIR and XPS study of Pt nanoparticle functionalization and interaction with alumina. Langmuir 2008, 24, 5832–5841. [Google Scholar] [CrossRef] [PubMed]
- Rani, K.V.; Sarma, B.; Sarma, A.K. Plasma pretreatment on tasar silk fabrics coated with Zno nanoparticles against antibacterial activity. Surf. Rev. Lett. 2018. [Google Scholar] [CrossRef]
- Pulit-Prociak, J.; Chwastowski, J.; Kucharski, A.; Banach, M. Functionalization of textiles with silver and zinc oxide nanoparticles. Appl. Surf. Sci. 2016, 385, 543–553. [Google Scholar] [CrossRef]
- Yang, B.C.; Zhao, C.M.; Xiao, M.D.; Wang, F.; Li, C.H.; Wang, J.F.; Yu, J.C. Loading metal nanostructures on cotton fabrics as recyclable catalysts. Small 2013, 9, 1003–1007. [Google Scholar] [CrossRef] [PubMed]
- Hofer, C.J.; Grass, R.N.; Schneider, E.M.; Hendriks, L.; Herzog, A.F.; Zeltner, M.; Günther, D.; Stark, W.J. Water dispersible surface-functionalized platinum/carbon nanorattles for size-selective catalysis. Chem. Sci. 2018, 9, 362. [Google Scholar] [CrossRef] [PubMed]
- Subramaniyan, S.A.; Sheet, S.; Vinothkannan, M.; Yoo, D.J.; Lee, Y.S.; Belal, S.A.; Shim, K.S. One-pot facile synthesis of Pt nanoparticles using cultural filtrate of microgravity simulated grown P. chrysogenum and their activity on bacteria and cancer cells. J. Nanosci. Nanotechnol. 2018, 18, 3110. [Google Scholar] [CrossRef] [PubMed]
- Aladpoosh, R.; Montazer, M. Nano-photo active cellulosic fabric through in situ phytosynthesis of star-like Ag/ZnO nanocomposites: Investigation and optimization of attributes associated with photocatalytic activity. Carbohydr. Polym. 2016, 141, 116–125. [Google Scholar] [CrossRef] [PubMed]
- Staszek, M.; Siegel, J.; Kolářová, K.; Rimpelová, S.; Švorčík, V. Formation and antibacterial action of Pt and Pd nanoparticles sputtered into liquid. Micro Nano Lett. 2014, 9, 778–781. [Google Scholar] [CrossRef]
- Fu, X.; Wang, Y.; Wu, N.; Gui, L.; Tang, Y. Surface modification of small platinum nanoclusters with alkylamine and alkylthiol: An xps study on the influence of organic ligands on the Pt 4f binding energies of small platinum nanoclusters. J. Colloid Interface Sci. 2001, 243, 326–330. [Google Scholar] [CrossRef]
- Wang, J.; Yin, G.; Shao, Y.; Zhang, S.; Wang, Z.; Gao, Y. Effect of carbon black support corrosion on the durability of Pt/C catalyst. J. Power Sources 2007, 171, 331–339. [Google Scholar] [CrossRef]
- Shao, J.; Liu, J.; Zheng, J.; Carr, C.M. X-ray photoelectron spectroscopic study of silk fibroin surface. Polym. Int. 2002, 51, 1479–1483. [Google Scholar] [CrossRef]
- Bradley, R.H.; Clackson, I.L.; Sykes, D.E. UV ozone modification of wool fibre surfaces. Appl. Surf. Sci. 1993, 72, 143–147. [Google Scholar] [CrossRef]
- Wang, Q.; Yanzhang, R.; Ren, X.; Zhu, H.; Zhang, M.; Du, M. Two-dimensional molybdenum disulfide and tungsten disulfide interleaved nanowalls constructed on silk cocoon-derived N-doped carbon fibers for hydrogen evolution reaction. Int. J. Hydrog. Energy 2016, 41, 21870–21882. [Google Scholar] [CrossRef]
- Zhang, J.; Cai, Y.; Zhong, Q.; Lai, D.; Yao, J. Porous nitrogen-doped carbon derived from silk fibroin protein encapsulating sulfur as a superior cathode material for high-performance lithium–sulfur batteries. Nanoscale 2015, 7, 17791–17797. [Google Scholar] [CrossRef] [PubMed]
- Goodenough, J.B.; Hamnett, A.; Kennedy, B.J.; Manoharan, R.; Weeks, S.A. Porous carbon anodes for the direct methanol fuel cell—I. The role of the reduction method for carbon supported platinum electrodes. Electrochim. Acta 1990, 35, 199–207. [Google Scholar] [CrossRef]
- Morazzoni, F.; Canevali, C.; Chiodini, N.; Mari, C.; Ruffo, R.; Scotti, R.; Armelao, L.; Tondello, E.; Depero, L.; Bontempi, E. Surface reactivity of nanostructured tin oxide and Pt-doped tin oxide as studied by EPR and XPS spectroscopies. Mater. Sci. Eng. C Mater. Biol. Appl. 2001, 15, 167–169. [Google Scholar] [CrossRef]
- Kirner, U.K.; Schierbaum, K.D.; Göpel, W. Interface-reactions of Pt/TiO2: Comparative electrical, XPS-, and AES-depth profile investigations. Fresenius J. Anal. Chem. 1991, 341, 416–420. [Google Scholar] [CrossRef]
- Kerrec, O.; Devilliers, D.; Groult, H.; Marcus, P. Study of dry and electrogenerated Ta2O5 and Ta/Ta2O5/Pt structures by XPS. Mater. Sci. Eng. B Solid State Mater. Adv. Technol. 1998, 55, 134–142. [Google Scholar] [CrossRef]
- Kakuta, N.; Bard, A.J.; Campion, A.; Fox, M.A.; Webber, S.E.; White, J.M. Surface analysis of semiconductor-incorporated polymer systems: 2—Pt-Nafion and Pt-CdS-Nafion. Surf. Interface Anal. 1985, 7, 295–298. [Google Scholar] [CrossRef]
- Kim, Y.-T.; Mitani, T. Surface thiolation of carbon nanotubes as supports: A promising route for the high dispersion of Pt nanoparticles for electrocatalysts. J. Catal. 2006, 238, 394–401. [Google Scholar] [CrossRef]
- Herves, P.; Perez-Lorenzo, M.; Liz-Marzan, L.M.; Dzubiella, J.; Lu, Y.; Ballauff, M. Catalysis by metallic nanoparticles in aqueous solution: Model reactions. Chem. Soc. Rev. 2012, 41, 5577–5587. [Google Scholar] [CrossRef] [PubMed]
- Barnes, W.L.; Dereux, A.; Ebbesen, T.W. Surface plasmon subwavelength optics. Nature 2003, 424, 824–830. [Google Scholar] [CrossRef] [PubMed]
- Liang, M.; Su, R.; Huang, R.; Qi, W.; Yu, Y.; Wang, L.; He, Z. Facile in situ synthesis of silver nanoparticles on procyanidin-grafted eggshell membrane and their catalytic properties. ACS Appl. Mater. Interfaces 2014, 6, 4638–4649. [Google Scholar] [CrossRef] [PubMed]
- Tang, B.; Li, J.L.; Fan, L.P.; Wang, X.G. Facile synthesis of silver submicrospheres and their applications. RSC Adv. 2015, 5, 98293–98298. [Google Scholar] [CrossRef]
- Tang, B.; Zhou, X.; Zeng, T.; Lin, X.; Zhou, J.; Ye, Y.; Wang, X. In situ synthesis of gold nanoparticles on wool powder and their catalytic application. Materials 2017, 10, 295. [Google Scholar] [CrossRef] [PubMed]
- Ai, L.; Yue, H.; Jiang, J. Environmentally friendly light-driven synthesis of ag nanoparticles in situ grown on magnetically separable biohydrogels as highly active and recyclable catalysts for 4-nitrophenol reduction. J. Mater. Chem. 2012, 22, 23447–23453. [Google Scholar] [CrossRef]
- Islam, M.T.; Saenz-Arana, R.; Wang, H.; Bernal, R.; Noveron, J.C. Green synthesis of gold, silver, platinum, and palladium nanoparticles reduced and stabilized by sodium rhodizonate and their catalytic reduction of 4-nitrophenol and methyl orange. New J. Chem. 2018, 42, 6472–6478. [Google Scholar] [CrossRef]
- Vaidya, M.Y.; McBain, A.J.; Butler, J.A.; Banks, C.E.; Whitehead, K.A. Antimicrobial efficacy and synergy of metal ions against enterococcus faecium, klebsiella pneumoniae and acinetobacter baumannii in planktonic and biofilm phenotypes. Sci. Rep. 2017, 7, 5911. [Google Scholar] [CrossRef] [PubMed]
- Manav, N.; Mishra, A.K.; Kaushik, N.K. In vitro antitumour and antibacterial studies of some Pt(IV) dithiocarbamate complexes. Spectroc. Acta A 2006, 65, 32–35. [Google Scholar] [CrossRef] [PubMed]

| Sample ID | PSF1 | PSF2 | PSF3 | PSF4 |
|---|---|---|---|---|
| Pt Content (mg g−1) | 3.50 | 4.39 | 8.58 | 9.37 |
| pH | 3 | 4 | 5 | 6 |
| Pt Content (mg g−1) | 8.60 | 8.58 | 1.81 | 0.68 |
© 2018 by the authors. Licensee MDPI, Basel, Switzerland. This article is an open access article distributed under the terms and conditions of the Creative Commons Attribution (CC BY) license (http://creativecommons.org/licenses/by/4.0/).
Share and Cite
Zou, F.; Zhou, J.; Zhang, J.; Li, J.; Tang, B.; Chen, W.; Wang, J.; Wang, X. Functionalization of Silk with In-Situ Synthesized Platinum Nanoparticles. Materials 2018, 11, 1929. https://doi.org/10.3390/ma11101929
Zou F, Zhou J, Zhang J, Li J, Tang B, Chen W, Wang J, Wang X. Functionalization of Silk with In-Situ Synthesized Platinum Nanoparticles. Materials. 2018; 11(10):1929. https://doi.org/10.3390/ma11101929
Chicago/Turabian StyleZou, Fan, Ji Zhou, Jin Zhang, Jingliang Li, Bin Tang, Wu Chen, Jinfeng Wang, and Xungai Wang. 2018. "Functionalization of Silk with In-Situ Synthesized Platinum Nanoparticles" Materials 11, no. 10: 1929. https://doi.org/10.3390/ma11101929
APA StyleZou, F., Zhou, J., Zhang, J., Li, J., Tang, B., Chen, W., Wang, J., & Wang, X. (2018). Functionalization of Silk with In-Situ Synthesized Platinum Nanoparticles. Materials, 11(10), 1929. https://doi.org/10.3390/ma11101929

